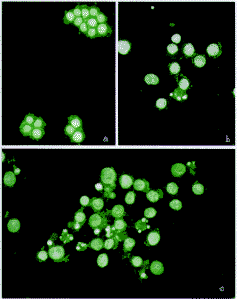

复方苦参水溶液体外对人结肠癌细胞SW480的影响
作者:周林 艾中立 刘志苏 钱群 何跃明
单位:周林 艾中立 刘志苏 钱群 何跃明(湖北医科大学附属第二医院普通外科,湖北 武汉 430071)
关键词:结肠肿瘤/治疗;复方苦参;中药;细胞凋亡
癌症000415
【摘要】目的:探讨复方苦参水溶液体外对结肠癌细胞的影响。方法:应用MTT法,生长曲线,荧光染色,流式细胞仪,透射电镜技术研究复方苦参水溶液体外对SW480细胞的增殖抑制及诱导凋亡作用。结果:复方苦参水溶液体外对SW480细胞有明显的抑制作用,而且这种抑制作用呈现浓度和时间的依赖性。30mg/ml中药作用SW480细胞48小时后,光镜及电镜下可见胞核固缩,荧光染色增强,胞核碎裂,凋亡小体形成等凋亡形态学变化。流式细胞仪检测到亚G1峰,其凋亡率为11.13%。细胞周期分析发现,经30mg/ml药物处理48小时后,S期细胞由对照组的25.41%上升到41.27%(P<0.01),G2/M期细胞由6.74%降至1.35%(P<0.01)。结论:复方苦参水溶液体外能够抑制SW480细胞增殖并且在一定浓度范围内诱导其凋亡,诱导凋亡可能是其发挥抗肿瘤作用的重要机制之一。
, http://www.100md.com
中图分类号:R735.34 文献标识码:A 文章编号:1000-467X(2000)04-0337-04
An in vitro study of effect of Kushen compound preparation on human colon cancer cell line SW480
ZHOU Lin AI Zhong-li LIU Zhi-su et al.
(Department of General Surgery of the Second Affiliated Hospital of Hubei Medical University, Wuhan 430071, P.R.China)
【Abstract】 Objective: To explore the effect of Kushen compound preparation on human cancer cell line SW480 in vitro. Methods: Inhibition of SW480 cell growth by Kushen compound preparation was determined by MTT assay and growth curve, and apoptosis was detected by morphological assay and flow cytometry (FCM). Results: The solution of Kushen compound preparation showed dose-dependent and time-dependent inhibitory effects on the proliferation in SW480 cell line. The cells treated with 30 mg/ml compoumd for 48 hours showed characters of apoptosis under light and electronic microscopy. Sub-G1 peak was detected by FCM, the ratio of apoptosis was 11.13% . The cell percent of S phrase increased from 25.41% to 41.27% (P<0.01), and that of G2/M phrase decreased from 6.74% to 1.35% (P< 0.01) after treatment. Conclusion: In vitro, Kushen compound preparation has growth inhibiting effect and may induce apoptosis in SW480 in a certain dose range, which may be one of the antineoplastic effects of Kushen compound preparation.
, 百拇医药
Key Words: Colon neoplasms; Therapy; Chinese herb; Cell apoptosis; Kushen compound preparation
结肠癌是一种常见的癌症,近年来其发病率有上升的趋势。目前,对于晚期转移或不可切除的结肠癌病人的化疗以及术后辅助性化疗仍以5-FU为主,但其总有效率仍不尽人意。中药治疗结肠癌以其毒性低,有一定疗效而日益引起人们的重视[1],但其抗癌机制的研究却少有报道。复方苦参水溶液是从苦参、黄芪、丹参等抗癌中草药中提取水溶液成分而成。我们用该复方水溶液直接作用于体外培养的人结肠癌细胞SW480,通过研究该药对SW480细胞的体外作用来探讨其抗癌机制。
1 材料和方法
1.1材料
复方苦参水溶液由我院制剂科制备,每毫升含浓度(mg/ml)2克生药,临用前过滤除菌,用培养液稀释至所需浓度。RPMI1640培养基,Gibco产品;MTT,Sigma公司产品;Hoechst33258,Sigma公司产品;碘化丙啶(PI),Sigma公司产品;胎牛血清,天津生化厂产品;SW480细胞来自武汉大学典型培养物保藏中心。
, http://www.100md.com
表1 复方苦参水溶液对SW480细胞抑制作用(n=8) 浓度(mg/ml)
A值(
±s)
抑制率(%)
0
0.847±0.029
0
1
0.834±0.025
1.5
10
0.668±0.026*
, 百拇医药
21.13
20
0.523±0.013*
38.25
40
0.331±0.021*
60.93
80
0.224±0.017*
73.55
160
0.119±0.021*
, http://www.100md.com
87.43
*P<0.01,实验组VS对照组
1.2方法
1.2.1复方苦参水溶液(以下简称中药)对结肠癌细胞的细胞毒作用:采用MTT比值法。取对数生长期大肠癌细胞调整至105/ml,接种于96孔板上,每孔0.2ml。置37℃,5%CO2培养24小时后,弃原培养液,加入含不同浓度中药培养液使终浓度分别为1mg/ml,10mg/ml,20mg/ml,40mg/ml,80mg/ml和160mg/ml,另设培养液对照组,每浓度重复8孔。作用72小时后,每孔加MTT20μl(5mg/ml)37℃4小时后,小心吸去上清,加入DMSO100μl,轻轻振荡后上酶标仪测定,参考波长490nm,实验波长570nm。按下式计算抑制率:抑制率(%)=(对照孔A值-实验孔A值)/对照孔A值×100%。
, http://www.100md.com
1.2.2中药对结肠癌细胞生长曲线的影响:取对数生长期细胞2×104置于25ml培养瓶中,培养24小时后,去培养液,换入含中药终浓度为20mg/ml和60mg/ml的培养液,对照组加等量培养液,连续培养5天,每天取3瓶细胞,以台盼蓝法计算活细胞数,取平均值,绘制生长曲线。
1.2.3中药诱导结肠癌细胞凋亡的研究:(1)荧光染色:收集细胞后用3∶1甲醇/冰醋酸固定、涂片,三蒸水冲洗,Hoechst33258(5μg/ml)染色,干燥后甘油封片,荧光显微镜观察拍照。(2)流式细胞仪分析:收集细胞后,用磷酸缓冲液(PBS)洗涤,4℃乙醇固定过夜,离心去乙醇,加入10g/LRNA酶200μl,37℃水浴15分钟,加入PI染色30分钟后,上流式细胞仪进行分析DNA含量和细胞周期。(3)透射电镜观察超微结构:用刮刀收集药物作用后的SW480细胞,2.5%戊二醇固定后,按常规法固定脱水、染色,制成超薄切片后上H-300电镜观察,记录观察结果并照相。
, 百拇医药
1.3资料统计
所有数据均用
±s表示,采用方差分析,P<0.05为显著性差异。
2 结果
2.1中药对SW480细胞的细胞毒作用
如表1所示,随着药物浓度的升高,中药对细胞的抑制率也越高。该药对细胞抑制作用呈浓度依赖性。见表1。
2.2中药对SW480细胞生长曲线的影响
如图1所示,随着药物浓度的升高,药物作用时间的延长,细胞生长抑制现象愈明显。较高药物浓度(60mg/ml)作用长时间后,细胞出现死亡,活细胞数目减少。见图1。
, 百拇医药
图1 复方苦参水溶液对SW480活细胞数的影响
2.3中药诱导SW480细胞凋亡的观察
2.3.1荧光染色形态学观察:30mg/ml及80mg/ml中药作用48小时后,荧光染色可见细胞核固缩,胞核碎裂等典型凋亡形态学改变。见图2。
图2中药诱导SW480细胞凋亡的荧光染色形态学观察
a.培养液对照组,胞核染色均匀(×200)
b.30mg/ml复方苦参处理组,可见部分细胞出现核浓缩、核碎裂(×200)
c.80mg/ml复方苦参处理组,可见较多细胞出现核碎裂(×200)
, 百拇医药
2.3.2流式细胞仪检测凋亡及细胞周期的改变:经30mg/ml和80mg/ml中药处理SW48048小时后,流式细胞仪DNA组方图上均可见G0/G1期前出现的亚G1峰(图3b、c),说明SW480细胞出现凋亡,其凋亡率分别为11.13%和26.64%,对照组凋亡率仅为2.07%(图3a)。而经160mg/ml中药处理48小时后,G0/G1期前却未见明显亚G1峰(图3d)。同时细胞周期分析可见处理后的S期细胞明显上升,G0/G1和G2/M期细胞明显下降,呈现S期阻滞(表2),说明该中药作用于S期细胞。见表2,见图3。
图3中药诱导SW480细胞凋亡的流式细胞仪检测结果
a.对照组b.30mg/ml复方苦参处理组,可见亚G1峰,凋亡率为11.13%c.80mg/ml复方苦参处理组,凋亡率为26.64%d.160mg/ml复方苦参处理组,未见明显亚G1峰
, 百拇医药
表2 复方苦参水溶液对SW480细胞周期的影响(%,n=5,
±s) 组别
G0/G1
S
G2/M
对照组
67.85±1.02
25.41±0.65
6.74±0.3
30mg/ml
57.38±0.84a
, 百拇医药
41.27±0.46a
1.35±0.03
80mg/ml
51.82±0.35ab
48.18±0.56ab
0ab
2.3.3透射电镜形态学检测结果:30mg/ml中药处理SW480细胞48小时后,电镜下可见部分细胞出现明显的凋亡形态学改变。见图4。
图4中药诱导SW480细胞凋亡的透射电镜形态学观察
, 百拇医药
a.对照组细胞,可见细胞生长良好,常染色质丰富,胞外有较多微绒毛(×7000)
b.30mg/ml中药处理48小时后,细胞核固缩、核染色质边聚,胞内有较多变性空泡,胞浆内可见凋亡小体(×7000)
c.30mg/ml中药处理48h后,大量凋亡小体形成
3 讨论
近年来,关于中药诱导肿瘤细胞凋亡的研究越来越多[2~4],但多为中药有效成分的提纯试剂,符合我国传统用药习惯的复方汤药是否也有同样的诱导肿瘤细胞凋亡的现象则极少有人报道。
复方苦参的主要成分为苦参、黄芪、丹参、半枝莲等。中医认为,苦参性寒味苦,有清热解毒的作用,为抗肿瘤常用中药。现代医学研究证实,苦参中所含苦参碱、氧化苦参碱等生物碱成分均有较好的抗癌活性[5]。我们研究发现,复方苦参水溶液体外对人结肠腺癌细胞株SW480有抑制生长作用;这种生长抑制作用呈现出时间和浓度上的依赖性,随着作用浓度的增加及作用时间的延长,这种抑制作用愈明显(表1,图1)。同时,我们还发现复方苦参体外有诱导SW480凋亡的作用。荧光染色显示中药处理后的细胞出现核浓缩,核碎裂(图2),流式细胞仪DNA直方图上出现亚G1峰,电镜显示出现凋亡小体(图4)。通过流式细胞仪定量分析,30mg/ml中药作用后细胞凋亡率为11.13%(图3b),80mg/ml中药诱导的凋亡率为26.64%(图3c),而经160mg/ml中药处理后的细胞凋亡不明显(图3d),可能是由于药物浓度太大,导致大量细胞坏死,染色质进一步降解有关。一般认为,较低的刺激引起凋亡,而过大的刺激导致坏死。上述结果表明该药诱导的凋亡作用是在一定浓度下发生的,过高的浓度主要引起坏死,与杨氏[6]的报道结果类似。细胞周期分析发现,30mg/ml中药作用48小时后,S期细胞由对照组的25.14%上升到41.27%(P<0.01),G2/M期细胞由6.74%降至1.35%(P<0.01);80mg/ml组则更是S期细胞升到48.18%(P<0.01),G2/M期细胞降至0(P<0.01)(表2)。提示该药具有明显S期阻滞作用,使进入G2/M期的细胞明显减少,从而抑制SW480生长和诱导其凋亡。近年来众多的研究表明,肿瘤的发生、发展不仅与肿瘤细胞分化异常、细胞增殖过度有关,而且与细胞凋亡减少有关[7]。目前临床上应用很多的抗肿瘤药如5-FU、顺铂、丝裂霉素等被发现均可诱导肿瘤细胞凋亡[8],诱导凋亡是其抗肿瘤的重要机制之一。由于肿瘤细胞较正常细胞对药物诱导的细胞凋亡更为敏感[9],在药物设计时可研究更特异性诱导肿瘤细胞凋亡的药物。复方苦参中到底是何成分有诱导凋亡作用尚不清楚。有学者发现[10],一些从中药中提取的生物碱能有效抑制肿瘤细胞生长,并且能诱导肿瘤细胞凋亡。复方苦参中所含的苦参碱类物质,可能就是诱导SW480细胞凋亡的主要成分。司维柯等[11]用苦参碱作用于K562细胞,发现当苦参碱浓度至1.0mg/ml时,K562细胞出现早期凋亡现象。
, http://www.100md.com
目前用于大肠癌的化疗药层出不穷,但探求高效、低毒、经济的化疗药仍是许多学者坚持不懈的追求目标。复方苦参中的几味药均为传统治疗结肠癌较为有效的中药。我们研究表明该药体外有抑制结肠癌细胞增殖和诱导其凋亡的作用,用现代的研究方法揭示诱导凋亡是其抗肿瘤的重要机制之一,也显示了复方苦参在结肠癌治疗方面具有一定潜力。
致谢:衷心感谢附二院制剂科吴荣才主任在中药制备方面给予的大力支持。
通讯作者:艾中立 Tel:86-27-87336033
[参考文献]
[1]潘志恒.近10年来中医药治疗大肠癌的研究进展[J].中国药学学报,1996,(1):16~17.
[2]杨骅,王仙平,郁琳琳,等.榄香烯抗癌作用与诱发肿瘤细胞凋亡[J].中华肿瘤杂志,1996,18(5):169~171.
, 百拇医药
[3]陈宏,张振书,张亚历.姜黄素诱导Lovo细胞凋亡[J].中国中医基础医学杂志,1999,5(3):32~34.
[4]Zheng S, Yang H, Zhang S, et al. Initial study on naturally occurring products from traditional Chinese herbs and vegetables for chemoprevention [J]. J Cell Biochem (Suppl), 1997, 27:106~ 112.
[5]许相儒,蒋纪恺.苦参及其生物碱抗肿瘤活性研究进展[J].中国中西医结合杂志,1998,18(5):314~316.
[6]杨惠玲,汪雪兰,吴义方,等.小柴胡汤对荷瘤鼠S180细胞生长和结构影响的研究[J].中国病理生理杂志,1998,14(3):278~281.
, 百拇医药
[7]涂水平,吴裕忻.细胞凋亡与胃肠肿瘤[J].内镜,1997,3(1):61~64.
[8]粟俭.药物诱导的肿瘤细胞凋亡研究进展[J].国外医学肿瘤学分册,1995,22(1):7~10.
[9]Collins RJ, Harmon BV, Souvlis T, et al. Effects of cycloheximide on B-chronic lymphocytic leukaemic and normal lymphocytes in vitro: induction of apoptosis [J]. Br J Cancer,1991, 64: 518~ 522.
[10]Hsu SH, Tsai TR, Lin CN, et al. Solamargine Purified from solanum incanum Chinese herb triggers gene expression of human TNFR1 which may lead to cell apoptosis [J].Biochem Biophys Res Commun, 1996, 229(1): 1~ 5.
[11]司维柯,韩风,秦建平,等.苦参提取液诱导K562细胞分化的细胞化学观察[J].中国组织化学与细胞化学杂志,1997,6(2):198~204.
收稿日期:1999-10-20
修回日期:1999-12-01, 百拇医药
单位:周林 艾中立 刘志苏 钱群 何跃明(湖北医科大学附属第二医院普通外科,湖北 武汉 430071)
关键词:结肠肿瘤/治疗;复方苦参;中药;细胞凋亡
癌症000415
【摘要】目的:探讨复方苦参水溶液体外对结肠癌细胞的影响。方法:应用MTT法,生长曲线,荧光染色,流式细胞仪,透射电镜技术研究复方苦参水溶液体外对SW480细胞的增殖抑制及诱导凋亡作用。结果:复方苦参水溶液体外对SW480细胞有明显的抑制作用,而且这种抑制作用呈现浓度和时间的依赖性。30mg/ml中药作用SW480细胞48小时后,光镜及电镜下可见胞核固缩,荧光染色增强,胞核碎裂,凋亡小体形成等凋亡形态学变化。流式细胞仪检测到亚G1峰,其凋亡率为11.13%。细胞周期分析发现,经30mg/ml药物处理48小时后,S期细胞由对照组的25.41%上升到41.27%(P<0.01),G2/M期细胞由6.74%降至1.35%(P<0.01)。结论:复方苦参水溶液体外能够抑制SW480细胞增殖并且在一定浓度范围内诱导其凋亡,诱导凋亡可能是其发挥抗肿瘤作用的重要机制之一。
, http://www.100md.com
中图分类号:R735.34 文献标识码:A 文章编号:1000-467X(2000)04-0337-04
An in vitro study of effect of Kushen compound preparation on human colon cancer cell line SW480
ZHOU Lin AI Zhong-li LIU Zhi-su et al.
(Department of General Surgery of the Second Affiliated Hospital of Hubei Medical University, Wuhan 430071, P.R.China)
【Abstract】 Objective: To explore the effect of Kushen compound preparation on human cancer cell line SW480 in vitro. Methods: Inhibition of SW480 cell growth by Kushen compound preparation was determined by MTT assay and growth curve, and apoptosis was detected by morphological assay and flow cytometry (FCM). Results: The solution of Kushen compound preparation showed dose-dependent and time-dependent inhibitory effects on the proliferation in SW480 cell line. The cells treated with 30 mg/ml compoumd for 48 hours showed characters of apoptosis under light and electronic microscopy. Sub-G1 peak was detected by FCM, the ratio of apoptosis was 11.13% . The cell percent of S phrase increased from 25.41% to 41.27% (P<0.01), and that of G2/M phrase decreased from 6.74% to 1.35% (P< 0.01) after treatment. Conclusion: In vitro, Kushen compound preparation has growth inhibiting effect and may induce apoptosis in SW480 in a certain dose range, which may be one of the antineoplastic effects of Kushen compound preparation.
, 百拇医药
Key Words: Colon neoplasms; Therapy; Chinese herb; Cell apoptosis; Kushen compound preparation
结肠癌是一种常见的癌症,近年来其发病率有上升的趋势。目前,对于晚期转移或不可切除的结肠癌病人的化疗以及术后辅助性化疗仍以5-FU为主,但其总有效率仍不尽人意。中药治疗结肠癌以其毒性低,有一定疗效而日益引起人们的重视[1],但其抗癌机制的研究却少有报道。复方苦参水溶液是从苦参、黄芪、丹参等抗癌中草药中提取水溶液成分而成。我们用该复方水溶液直接作用于体外培养的人结肠癌细胞SW480,通过研究该药对SW480细胞的体外作用来探讨其抗癌机制。
1 材料和方法
1.1材料
复方苦参水溶液由我院制剂科制备,每毫升含浓度(mg/ml)2克生药,临用前过滤除菌,用培养液稀释至所需浓度。RPMI1640培养基,Gibco产品;MTT,Sigma公司产品;Hoechst33258,Sigma公司产品;碘化丙啶(PI),Sigma公司产品;胎牛血清,天津生化厂产品;SW480细胞来自武汉大学典型培养物保藏中心。
, http://www.100md.com
表1 复方苦参水溶液对SW480细胞抑制作用(n=8) 浓度(mg/ml)
A值(
抑制率(%)
0
0.847±0.029
0
1
0.834±0.025
1.5
10
0.668±0.026*
, 百拇医药
21.13
20
0.523±0.013*
38.25
40
0.331±0.021*
60.93
80
0.224±0.017*
73.55
160
0.119±0.021*
, http://www.100md.com
87.43
*P<0.01,实验组VS对照组
1.2方法
1.2.1复方苦参水溶液(以下简称中药)对结肠癌细胞的细胞毒作用:采用MTT比值法。取对数生长期大肠癌细胞调整至105/ml,接种于96孔板上,每孔0.2ml。置37℃,5%CO2培养24小时后,弃原培养液,加入含不同浓度中药培养液使终浓度分别为1mg/ml,10mg/ml,20mg/ml,40mg/ml,80mg/ml和160mg/ml,另设培养液对照组,每浓度重复8孔。作用72小时后,每孔加MTT20μl(5mg/ml)37℃4小时后,小心吸去上清,加入DMSO100μl,轻轻振荡后上酶标仪测定,参考波长490nm,实验波长570nm。按下式计算抑制率:抑制率(%)=(对照孔A值-实验孔A值)/对照孔A值×100%。
, http://www.100md.com
1.2.2中药对结肠癌细胞生长曲线的影响:取对数生长期细胞2×104置于25ml培养瓶中,培养24小时后,去培养液,换入含中药终浓度为20mg/ml和60mg/ml的培养液,对照组加等量培养液,连续培养5天,每天取3瓶细胞,以台盼蓝法计算活细胞数,取平均值,绘制生长曲线。
1.2.3中药诱导结肠癌细胞凋亡的研究:(1)荧光染色:收集细胞后用3∶1甲醇/冰醋酸固定、涂片,三蒸水冲洗,Hoechst33258(5μg/ml)染色,干燥后甘油封片,荧光显微镜观察拍照。(2)流式细胞仪分析:收集细胞后,用磷酸缓冲液(PBS)洗涤,4℃乙醇固定过夜,离心去乙醇,加入10g/LRNA酶200μl,37℃水浴15分钟,加入PI染色30分钟后,上流式细胞仪进行分析DNA含量和细胞周期。(3)透射电镜观察超微结构:用刮刀收集药物作用后的SW480细胞,2.5%戊二醇固定后,按常规法固定脱水、染色,制成超薄切片后上H-300电镜观察,记录观察结果并照相。
, 百拇医药
1.3资料统计
所有数据均用
2 结果
2.1中药对SW480细胞的细胞毒作用
如表1所示,随着药物浓度的升高,中药对细胞的抑制率也越高。该药对细胞抑制作用呈浓度依赖性。见表1。
2.2中药对SW480细胞生长曲线的影响
如图1所示,随着药物浓度的升高,药物作用时间的延长,细胞生长抑制现象愈明显。较高药物浓度(60mg/ml)作用长时间后,细胞出现死亡,活细胞数目减少。见图1。
, 百拇医药
图1 复方苦参水溶液对SW480活细胞数的影响
2.3中药诱导SW480细胞凋亡的观察
2.3.1荧光染色形态学观察:30mg/ml及80mg/ml中药作用48小时后,荧光染色可见细胞核固缩,胞核碎裂等典型凋亡形态学改变。见图2。
图2中药诱导SW480细胞凋亡的荧光染色形态学观察
a.培养液对照组,胞核染色均匀(×200)
b.30mg/ml复方苦参处理组,可见部分细胞出现核浓缩、核碎裂(×200)
c.80mg/ml复方苦参处理组,可见较多细胞出现核碎裂(×200)
, 百拇医药
2.3.2流式细胞仪检测凋亡及细胞周期的改变:经30mg/ml和80mg/ml中药处理SW48048小时后,流式细胞仪DNA组方图上均可见G0/G1期前出现的亚G1峰(图3b、c),说明SW480细胞出现凋亡,其凋亡率分别为11.13%和26.64%,对照组凋亡率仅为2.07%(图3a)。而经160mg/ml中药处理48小时后,G0/G1期前却未见明显亚G1峰(图3d)。同时细胞周期分析可见处理后的S期细胞明显上升,G0/G1和G2/M期细胞明显下降,呈现S期阻滞(表2),说明该中药作用于S期细胞。见表2,见图3。
图3中药诱导SW480细胞凋亡的流式细胞仪检测结果
a.对照组b.30mg/ml复方苦参处理组,可见亚G1峰,凋亡率为11.13%c.80mg/ml复方苦参处理组,凋亡率为26.64%d.160mg/ml复方苦参处理组,未见明显亚G1峰
, 百拇医药
表2 复方苦参水溶液对SW480细胞周期的影响(%,n=5,
G0/G1
S
G2/M
对照组
67.85±1.02
25.41±0.65
6.74±0.3
30mg/ml
57.38±0.84a
, 百拇医药
41.27±0.46a
1.35±0.03
80mg/ml
51.82±0.35ab
48.18±0.56ab
0ab
2.3.3透射电镜形态学检测结果:30mg/ml中药处理SW480细胞48小时后,电镜下可见部分细胞出现明显的凋亡形态学改变。见图4。
图4中药诱导SW480细胞凋亡的透射电镜形态学观察
, 百拇医药
a.对照组细胞,可见细胞生长良好,常染色质丰富,胞外有较多微绒毛(×7000)
b.30mg/ml中药处理48小时后,细胞核固缩、核染色质边聚,胞内有较多变性空泡,胞浆内可见凋亡小体(×7000)
c.30mg/ml中药处理48h后,大量凋亡小体形成
3 讨论
近年来,关于中药诱导肿瘤细胞凋亡的研究越来越多[2~4],但多为中药有效成分的提纯试剂,符合我国传统用药习惯的复方汤药是否也有同样的诱导肿瘤细胞凋亡的现象则极少有人报道。
复方苦参的主要成分为苦参、黄芪、丹参、半枝莲等。中医认为,苦参性寒味苦,有清热解毒的作用,为抗肿瘤常用中药。现代医学研究证实,苦参中所含苦参碱、氧化苦参碱等生物碱成分均有较好的抗癌活性[5]。我们研究发现,复方苦参水溶液体外对人结肠腺癌细胞株SW480有抑制生长作用;这种生长抑制作用呈现出时间和浓度上的依赖性,随着作用浓度的增加及作用时间的延长,这种抑制作用愈明显(表1,图1)。同时,我们还发现复方苦参体外有诱导SW480凋亡的作用。荧光染色显示中药处理后的细胞出现核浓缩,核碎裂(图2),流式细胞仪DNA直方图上出现亚G1峰,电镜显示出现凋亡小体(图4)。通过流式细胞仪定量分析,30mg/ml中药作用后细胞凋亡率为11.13%(图3b),80mg/ml中药诱导的凋亡率为26.64%(图3c),而经160mg/ml中药处理后的细胞凋亡不明显(图3d),可能是由于药物浓度太大,导致大量细胞坏死,染色质进一步降解有关。一般认为,较低的刺激引起凋亡,而过大的刺激导致坏死。上述结果表明该药诱导的凋亡作用是在一定浓度下发生的,过高的浓度主要引起坏死,与杨氏[6]的报道结果类似。细胞周期分析发现,30mg/ml中药作用48小时后,S期细胞由对照组的25.14%上升到41.27%(P<0.01),G2/M期细胞由6.74%降至1.35%(P<0.01);80mg/ml组则更是S期细胞升到48.18%(P<0.01),G2/M期细胞降至0(P<0.01)(表2)。提示该药具有明显S期阻滞作用,使进入G2/M期的细胞明显减少,从而抑制SW480生长和诱导其凋亡。近年来众多的研究表明,肿瘤的发生、发展不仅与肿瘤细胞分化异常、细胞增殖过度有关,而且与细胞凋亡减少有关[7]。目前临床上应用很多的抗肿瘤药如5-FU、顺铂、丝裂霉素等被发现均可诱导肿瘤细胞凋亡[8],诱导凋亡是其抗肿瘤的重要机制之一。由于肿瘤细胞较正常细胞对药物诱导的细胞凋亡更为敏感[9],在药物设计时可研究更特异性诱导肿瘤细胞凋亡的药物。复方苦参中到底是何成分有诱导凋亡作用尚不清楚。有学者发现[10],一些从中药中提取的生物碱能有效抑制肿瘤细胞生长,并且能诱导肿瘤细胞凋亡。复方苦参中所含的苦参碱类物质,可能就是诱导SW480细胞凋亡的主要成分。司维柯等[11]用苦参碱作用于K562细胞,发现当苦参碱浓度至1.0mg/ml时,K562细胞出现早期凋亡现象。
, http://www.100md.com
目前用于大肠癌的化疗药层出不穷,但探求高效、低毒、经济的化疗药仍是许多学者坚持不懈的追求目标。复方苦参中的几味药均为传统治疗结肠癌较为有效的中药。我们研究表明该药体外有抑制结肠癌细胞增殖和诱导其凋亡的作用,用现代的研究方法揭示诱导凋亡是其抗肿瘤的重要机制之一,也显示了复方苦参在结肠癌治疗方面具有一定潜力。
致谢:衷心感谢附二院制剂科吴荣才主任在中药制备方面给予的大力支持。
通讯作者:艾中立 Tel:86-27-87336033
[参考文献]
[1]潘志恒.近10年来中医药治疗大肠癌的研究进展[J].中国药学学报,1996,(1):16~17.
[2]杨骅,王仙平,郁琳琳,等.榄香烯抗癌作用与诱发肿瘤细胞凋亡[J].中华肿瘤杂志,1996,18(5):169~171.
, 百拇医药
[3]陈宏,张振书,张亚历.姜黄素诱导Lovo细胞凋亡[J].中国中医基础医学杂志,1999,5(3):32~34.
[4]Zheng S, Yang H, Zhang S, et al. Initial study on naturally occurring products from traditional Chinese herbs and vegetables for chemoprevention [J]. J Cell Biochem (Suppl), 1997, 27:106~ 112.
[5]许相儒,蒋纪恺.苦参及其生物碱抗肿瘤活性研究进展[J].中国中西医结合杂志,1998,18(5):314~316.
[6]杨惠玲,汪雪兰,吴义方,等.小柴胡汤对荷瘤鼠S180细胞生长和结构影响的研究[J].中国病理生理杂志,1998,14(3):278~281.
, 百拇医药
[7]涂水平,吴裕忻.细胞凋亡与胃肠肿瘤[J].内镜,1997,3(1):61~64.
[8]粟俭.药物诱导的肿瘤细胞凋亡研究进展[J].国外医学肿瘤学分册,1995,22(1):7~10.
[9]Collins RJ, Harmon BV, Souvlis T, et al. Effects of cycloheximide on B-chronic lymphocytic leukaemic and normal lymphocytes in vitro: induction of apoptosis [J]. Br J Cancer,1991, 64: 518~ 522.
[10]Hsu SH, Tsai TR, Lin CN, et al. Solamargine Purified from solanum incanum Chinese herb triggers gene expression of human TNFR1 which may lead to cell apoptosis [J].Biochem Biophys Res Commun, 1996, 229(1): 1~ 5.
[11]司维柯,韩风,秦建平,等.苦参提取液诱导K562细胞分化的细胞化学观察[J].中国组织化学与细胞化学杂志,1997,6(2):198~204.
收稿日期:1999-10-20
修回日期:1999-12-01, 百拇医药